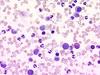

Hematopoiesis Flashcards
Hematopoiesis
the process by which blood cells are formed from hematopoietic stem cells (HSCs)
HSC to myeloid stem cell stimuli
IL-1
IL-3
IL-6
SCF
G-CSF
HSC to lymphoid stem cell stimuli
IL-1
IL-6
SCF
FLT-3L
Myeloid lineage
RBC
Platelets
Monocytes
Neutrophils
Eosinophils
Basophils
RBC formation pathway
BFU-E –> Proerythroblast –> RBC
*IL-3 and EPO
Platelet formation pathway
CFU-Mega –> Megakaryocyte –> Platelet
*IL-3, IL-11, and TPO
Monocyte formation pathway
CFU-GM –> Monoblast –> Monocyte
*IL-3, GM-CSF, and M-CSF

Neutrophil formation pathway
CFU-GM –> Myeloblast –> Neutrophil
*IL-3, GM-CSF, and G-CSF

Eosinophil formation pathway
Eosinophilic myeloblast –> Eosinophil
*IL-3, IL-5, and GM-CSF

Basophil formation pathway
Basophilic myeloblast –> Basophil
*IL-3 and IL-4

Lymphoid lineage
B cells
T cells
NK cells
B cell formation pathway
Pre-B cell –> B Lymphoblast –> B cell
*IL-1, IL-2, IL-4, IL-5, and IL-6

T cell formation pathway
Prothymocyte –> T Lymphoblast –> T cell
*IL-2 and IL-4

Prenatal hematopoiesis
Yolk sac (early)
Liver**
Spleen*
Bone marrow (late)
Postnatal hematopoiesis (child)
*before puberty
Tibia
Femur
Ribs
Sternum
Vertebrae and pelvis
Skull
Postnatal hematopoiesis (adult)
*after puberty
Ribs
Sternum
Vertebrae and pelvis
Skull
Hematopoietic cell compartment of bone marrow
highly vascular
contains hematopoietic stem cells (duh)
Marrow stromal compartment of bone marrow
Endothelial cell barrier (fenestrated)
Adipocytes for energy
Stromal cells and fibroblasts for structure
Macrophages to remove dead cells
Hematopoietic growth factors produced here
G-CSF
Given as treatment for neutropenia after chemotherapy or bone marrow transplant
Erythropoietin (EPO)
Produced by the kidneys
RBC formation
Agonists used as anemia treatment
Thrombopoietin (TPO)
Produced by the liver
Megakaryocyte and platelet formation
Agonists used as clotting disorder treatment
Reticulocyte
enlarged immature erythrocytes with residual RER

Metamyelocyte
Juvenile granulocyte with an indented nucleus

Buffy coat
Leukocytes and platelets